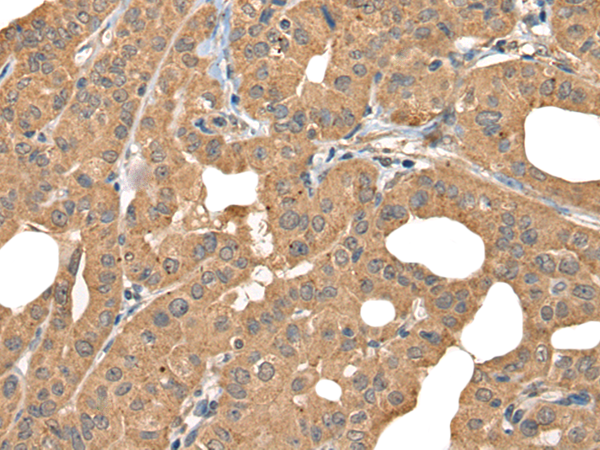
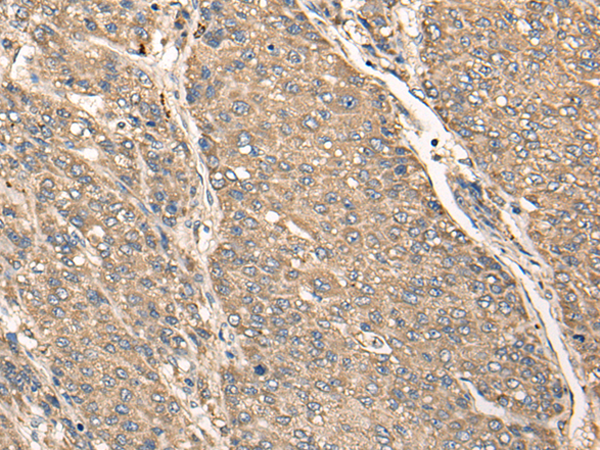

-
分类: 科研抗体货号: P09397别名: TNPS; COSMC; MST143; C1GALT2; HSPC067; C38H2-L1应用: IHC反应种属: Human, Mouse, Rat
-
分类: 科研抗体货号: P09381别名: G10; EDG2; Cwc14; EDG-2; fSAP17; YCR063W应用: WB,IHC反应种属: Human, Mouse, Rat
-
分类: 科研抗体货号: P09366别名: DPGM应用: WB,IHC反应种属: Human, Mouse
-
分类: 科研抗体货号: P09396别名: MIC1; Mic-1; WDR98; C18orf8; HsT2591应用: IHC反应种属: Human, Mouse
-
分类: 科研抗体货号: P09380别名: BTN9.2应用: IHC反应种属: Human
-
分类: 科研抗体货号: P09365别名: CGI-143应用: IHC反应种属: Human, Mouse
-
分类: 科研抗体货号: P09394别名: C18orf1应用: IHC反应种属: Human, Mouse
-
分类: 科研抗体货号: P09379别名: BT; BTN; BTN1应用: WB,IHC反应种属: Human, Mouse
-
分类: 科研抗体货号: P09388别名: CCDC176; C14orf45应用: IHC反应种属: Human
-
分类: 科研抗体货号: P09393别名:应用: IHC反应种属: Human

鄂公网安备42018502007531号
鄂公网安备42018502007531号

